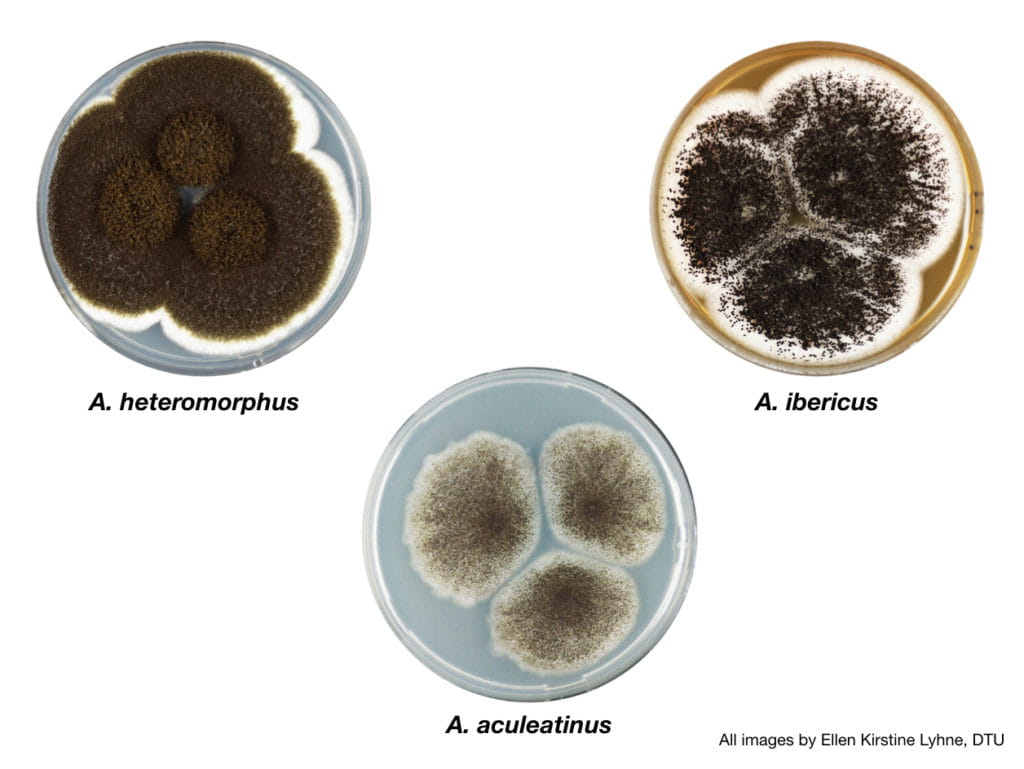
A. niger section Nigri fungi sequenced and analyzed for this study (clockwise from top left): A. heteromorphus, A. ibericus and A aculeatinus. (All images by Ellen Kirstine Lyhne, DTU.)

Spotlighting Differences in Closely-Related Species
There are millions of fungal species, and those few hundred found in the Aspergillus genus play important roles in areas ranging from industrial production to agricultural plant pathogens. A team led by scientists at the Technical University of Denmark, the U.S. Department of Energy (DOE) Joint Genome Institute (JGI), a DOE Office of Science User Facility, and the Joint Bioenergy Institute (JBEI), a DOE Bioenergy Research Center, present the first large analysis of an Aspergillus fungal subgroup, section Nigri.
Read more about Spotlighting Differences in Closely-Related Species
Researchers Switch Material from One State to Another with a Single Flash of Light
Scientists from the Department of Energy’s SLAC National Accelerator Laboratory and the Massachusetts Institute of Technology have demonstrated a surprisingly simple way of flipping a material from one state into another, and then back again, with single flashes of laser light.
Read more about Researchers Switch Material from One State to Another with a Single Flash of Light
Surprise Finding: Discovering a Previously Unknown Role for a Source of Magnetic Fields
Magnetic forces ripple throughout the universe, from the fields surrounding planets to the gasses filling galaxies, and can be launched by a phenomenon called the Biermann battery effect. Now scientists at the U.S. Department of Energy’s (DOE) Princeton Plasma Physics Laboratory (PPPL) have found that this phenomenon may not only generate magnetic fields, but can sever them to trigger magnetic reconnection – a remarkable and surprising discovery.
Read more about Surprise Finding: Discovering a Previously Unknown Role for a Source of Magnetic Fields
STAR Detector on the Move
How long does it take to roll a twelve-hundred-ton detector one hundred feet? In late August, it took 10 hours for the STAR detector to roll from its regular spot in the interaction region of the Relativistic Heavy Ion Collider (RHIC) to the assembly building to undergo maintenance. It’s all part of a program to keep this giant multi-purpose particle detector (kind of like a giant 3D digital camera) in tip-top condition for capturing subatomic smashups at RHIC, a DOE Office of Science user facility for nuclear physics research at the U.S. Department of Energy’s (DOE) Brookhaven National Laboratory.
Read more about STAR Detector on the Move
Scientists Find Unusual Behavior in Topological Material
Argonne scientists have identified a new class of topological materials made by inserting transition metal atoms into the atomic lattice of a well-known two-dimensional material.
Read more about Scientists Find Unusual Behavior in Topological Material
Genetic Behavior Reveals Cause of Death in Poplars Essential to Ecosystem, Industry
Scientists studying a valuable, but vulnerable, species of poplar have identified the genetic mechanism responsible for the species’ inability to resist a pervasive and deadly disease.
Read more about Genetic Behavior Reveals Cause of Death in Poplars Essential to Ecosystem, Industry
Pushing the (Extra Cold) Frontiers of Superconducting Science
Ruslan Prozorov, a physicist at the U.S. Department of Energy’s Ames Laboratory, and his research team have developed a method to measure magnetic properties of superconducting and magnetic materials that exhibit unusual quantum behavior at very low temperatures in high magnetic fields.
Read more about Pushing the (Extra Cold) Frontiers of Superconducting Science
ORNL Researcher Kate Page's Athletic Past Accents Value of Collaboration
Neutron scattering scientist Katharine Page believes in team work – as a staff scientist at Oak Ridge National Laboratory, a lead on the DISCOVER project, an IDREAM team member, and a mentor.
Read more about ORNL Researcher Kate Page's Athletic Past Accents Value of Collaboration
ESnet's Network, Software Help SLAC Researchers in Record-Setting Transfer of 1 Petabyte of Data
Using a 5,000-mile network loop operated by ESnet, researchers at the Department of Energy's SLAC National Accelerator Laboratory (SLAC) and Zettar Inc. recently transferred 1 petabyte in 29 hours, with encryption and checksumming, beating last year's record by 5 hours, an almost 15 percent improvement.
Read more about ESnet's Network, Software Help SLAC Researchers in Record-Setting Transfer of 1 Petabyte of Data
Computing Genes to Support Living Clean
ORNL computational systems biologist Dan Jacobson and OLCF computational scientist Wayne Joubert are part of a team that was named a finalist for the 2018 Gordon Bell Prize for its work to advance genomic science on the Summit supercomputer.
Read more about Computing Genes to Support Living Clean
Battery Mainstay Headed for High-tech Makeover
Under the terms of a new agreement signed with the U.S. Department of Energy’s Argonne National Laboratory, 14 members of the Advanced Lead Acid Battery Consortium (ALABC) have joined forces with Electric Applications to use the bright x-ray beams at the laboratory’s Advanced Photon Source to investigate the further potential of lead batteries.
Read more about Battery Mainstay Headed for High-tech Makeover
Fermilab Scientists to Look for Dark Matter Using Quantum Technology
Fermilab’s Aaron Chou is leading a multi-institutional consortium to apply the techniques of quantum metrology to the problem of detecting axion dark matter.
Read more about Fermilab Scientists to Look for Dark Matter Using Quantum Technology

